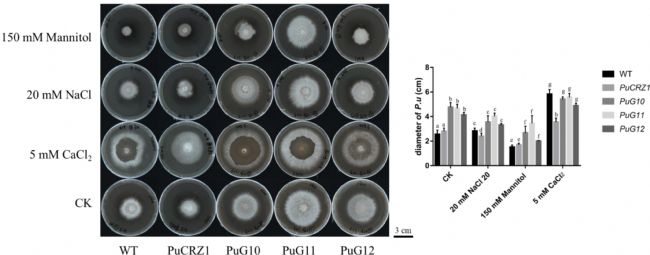
3. 菌株生長形態.png

豬苓(Polyporus umbellatus)是一種可食用的蘑菇,也是我國常用的菌類藥材之一,至今已有2000多年的藥用歷史,在《神農本草經》、《本草綱目》、《本草求真》等典籍中均有記載。豬苓具有利尿、抗菌作用,近年來研究還發現具有抗癌作用。當前醫藥衛生業對豬苓的需求量逐年增加。但是,豬苓的野生資源越來越少,而且種植周期較長,單產較低。豬苓具有產生菌核的能力,然而,其菌核形成的分子機制尚不清楚。因此,研究豬苓的生長發育及其調控機制,發展優質高產的豬苓種系和栽培技術,將有助于緩解豬苓供應緊張的問題。
2023年4月6日,中國中醫科學院中藥資源中心黃璐琦院士/袁媛研究員課題組的研究成果,發表在Frontiers in Microbiology期刊上(影響因子6.064),文章題目為“PuCRZ1, an C2H2 transcription factor from Polyporus umbellatus, positively regulates mycelium response to osmotic stress”。該研究使用DNA親和純化測序(DAP-seq)技術鑒定了豬苓中一個C2H2轉錄因子的結合基序及其靶基因,揭示了PuCRZ1參與調控豬苓菌絲生長以及滲透脅迫耐受的分子機制。

CRZ1(鈣調神經磷酸酶反應性鋅指轉錄因子)是C2H2家族轉錄因子,參與Ca2+-鈣調神經磷酸酶信號通路,具有調節菌核形成、維持離子穩態和應對脅迫等功能。CRZ1同源物都具有一個或多個特征性C2H2鋅指結構域,且它們的功能和調控基因在不同物種之間存在差異。目前,對于擔子菌CRZ1基因的研究還很少,僅在靈芝中進行過研究。
該研究首先鑒定了豬苓基因組中包含28個C2H2轉錄因子。qRT-PCR檢測發現,其中13個基因的轉錄水平在菌絲體和菌核之間存在差異,包括PuCRZ1。PuCRZ1基因全長801 bp,編碼了一個包含266個氨基酸的蛋白質,是一個核定位蛋白。

圖1. 通過DAP-seq鑒定PuCRZ1在全基因組的靶基因。
通過DAP-seq分析,鑒定到了PuCRZ1的保守結合基序為GTGGCG。KEGG富集分析發現,peak相關基因在抗生素生物合成、次級代謝產物生物合成、類固醇生物合成、自噬和內吞作用等信號通路中顯著富集,并從KEGG通路顯著富集的基因中發現了12個可能與豬苓菌核形成相關的基因。于是,進一步采用qRT-PCR鑒定到3個在菌絲體和菌核之間存在顯著差異表達的靶基因PuG10、PuG11、PuG12。酵母單雜交(Y1H)和凝膠阻滯實驗(EMSA)進一步驗證了PuCRZ1可以結合到PuG10、PuG11和PuG12的啟動子區域。
圖2. 在不同處理條件下,轉基因豬苓菌株的菌落形態和生長速率。
在酵母中過表達PuCRZ1基因后,降低了酵母細胞對NaCl和CaCl2的敏感性。之后,通過農桿菌介導的遺傳轉化,在豬苓中分別構建了過表達PuCRZ1、PuG10、PuG11和PuG12的轉基因菌株。然后,分別接種到20 mM NaCl、5 mM CaCl2、150 mM甘露醇培養基上。生長30天后,觀察發現PuCRZ1過表達菌株在NaCl和CaCl2培養基中的菌落直徑小于野生型菌株(WT),表明PuCRZ1過表達菌株對Na+和Ca2+更敏感。PuG10、PuG11、PuG12過表達菌株在NaCl和CaCl2培養基中的菌落直徑無明顯差別,卻在對照培養基和甘露醇培養基上均明顯大于WT菌株,其中PuG11過表達菌株的菌落直徑最大。這表明PuCRZ1調控的三個靶基因PuG10、PuG11、PuG12均可以提高菌絲體生長速度和對甘露醇脅迫的耐受性。以上結果表明PuCRZ1基因不直接調節對離子和滲透脅迫的耐受性,而是通過其靶基因對脅迫作出反應。
此外,還發現PuG11基因編碼的蛋白含有FYVE結構域,這是一種鋅指結合結構域。因此,該研究擴展了對真菌中含有FYVE結構域蛋白的功能和機制的理解。

圖3. CRZ1及其靶基因在Ca2+-鈣調神經磷酸酶信號通路中的調控機制圖。
總結:該研究首次將DAP-seq技術應用于藥用真菌的研究,為基因及分子間相互作用研究提供了新的技術借鑒。該研究揭示了PuCRZ1-鈣調神經磷酸酶信號通路在豬苓菌絲體生長以及滲透脅迫耐受中起重要作用,填補了國際上對豬苓CRZ1以及含FYVE結構域蛋白功能研究的空白,也為深入開展豬苓菌核形成機制的研究提供了理論依據。
論文鏈接:https://doi.org/10.3389/fmicb.2023.1131605
DAP-seq高通量地檢測轉錄因子在基因組上的結合位點,鑒定下游靶基因。藍景科信擁有100+物種,1000+轉錄因子的DAP-seq實驗經驗。我們使用該技術已助力客戶在許多期刊成功發表文章,例如:Molecular Plant,The Plant Cell,Plant Physiology,Plant Biotechnology Journal,Journal of Integrative Plant Biology,New Phytologist等。